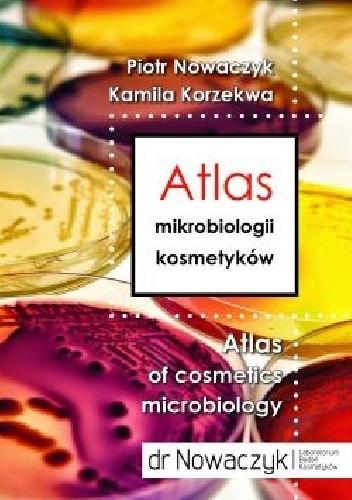
Atlas mikrobiologii kosmetyków

Kategorie
Andrea Harvey, Roman Lechowski, Séverine Tasker, Praca Zbiorowa
Koty. Weterynaryjna praktyka kliniczna
Konieczność stworzenia tego rodzaju podręcznika była w pełni oczywista, ponieważ już wiele lat temu koty wyparły psy w roli najczęściej …
Rosina Sonnenschmidt
Nerki i pęcherz. Oczyszczanie, filtracja, wytwarzanie hormonów i witaminy D
Autorka, najpopularniejsza terapeutka holistyczna, łączy Tradycyjną Medycynę Chińską oraz terapie zachodnie pozwalające przywrócić zdrowie nerek i pęcherza. Dzięki tej książce …
Magdalena Fikus
O życiu na żywo. Biologia według "Delty"
Zbiór felietonów, pióra znakomitej popularyzatorki nauki prof. Magdaleny Fikus, publikowanych na łamach miesięcznika Delta w latach 2010?2018. Autorka pisze m.in. …
Karl Shuker
Czy prehistoryczne zwierzęta przetrwały? Dinozaury i potwory mórz i jezior
Kultowy bestseller światowego autorytetu kryptozoologii Czy pradawne zwierzęta uważane za wymarłe w czasach prehistorycznych nadal żyją? Książka Czy prehistoryczne zwierzęta …
Kamila Korzekwa, Piotr Nowaczyk
Atlas mikrobiologii kosmetyków
Jego adresatami są pracownicy działów kontroli jakości przedsiębiorstw, w tym laboratoriów mikrobiologicznych, którzy w swojej codziennej pracy zajmują się badaniami …
Mark Maslin
Zmiany klimatu
Zmiany klimatu w przystępny sposób wyjaśniają, w jaki sposób człowiek wpływa na klimat planety. Teoria dotycząca zmian klimatu jest jedną …
Wiktor Tkaczyński Jan, Elżbieta Sztorc, Marek Świstak, Jan Wiktor Tkaczyński
Projekty europejskie. Praktyczne aspekty pozyskiwania i rozliczania dotacji unijnych
oJak uniknąć dyskwalifikacji projektu ubiegając się o jego dofinansowanie? o Jak wygląda praktyczne przygotowanie poszczególnych elementów składowych projektów europejskich? o …
Marek Jabłoński
Kompetencje pracownicze w organizacji uczącej się
Kompetencje pracownicze w ogranizacji uczącej się. Metody doskonalenia i rozwoju Kompetencje pracownicze są obecnie jednym z głównych czynników warunkujących uzyskanie …
Grzegorz Michalski
Wprowadzenie do zarządzania finansami przedsiębiorstw
Autor podręcznika prezentuje podstawowe zagadnienia z zakresu zarządzania finansami przedsiębiorstwa i mechanizmy ich funkcjonowania. W licznych przykładach w bardzo przystępny …
Bronisław Micherda
Ewolucja prawnych rozwiązań współczesnej rachunkowości
W książce podjęto niezwykle ważny problem, jakim jest proces ewolucji rachunkowości we współczesnej gospodarce rynkowej, w tym także gospodarce polskiej. …
Jankowska Agnieszka, Knopik Robert, Kierzkowski Tomasz
Fundusze strukturalne oraz Fundusz Spójności
Pierwsza na rynku tak kompleksowa interpretacja obowiązującego unijnego prawodawstwa dotyczącego funduszy strukturalnych oraz funduszu spójności wraz z analizą porównawczą dla …
Tomasz Maślanka
Przepływy pieniężne w zarządzaniu finansami przedsiębiorstw
W książce szeroko zaprezentowano wykorzystanie rachunku przepływów pieniężnych w analizie finansowej oraz w prognozowaniu upadłości polskich przedsiębiorstw. Zagadnienia te zostały …
Używamy plików cookie, aby poprawić Twoje doświadczenie na stronie.
Pomagają nam zrozumieć, jak odwiedzający wchodzą w interakcję ze stroną.
Używane do dostarczania reklam bardziej odpowiednich dla Ciebie.
Pozwalają na zapamiętywanie Twoich preferencji i ustawień.
Pomagają dostosować treść do Twoich preferencji.